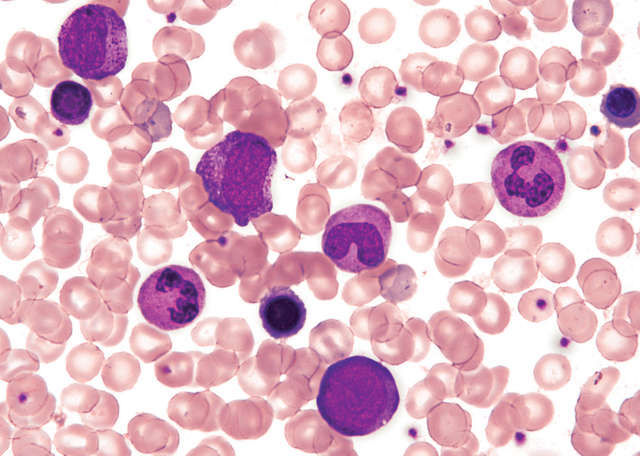

DS-Fi3 on Nikon Upright Microscope ECLIPSE Ni-U
High Resolution Image
A CMOS high-density 5.9-megapixel sensor produces high-resolution images. DS-Fi3 allows fast focusing at high resolution, and east capture images in all types of observation methods such as brightfield, differential interference contrast, and phase contrast